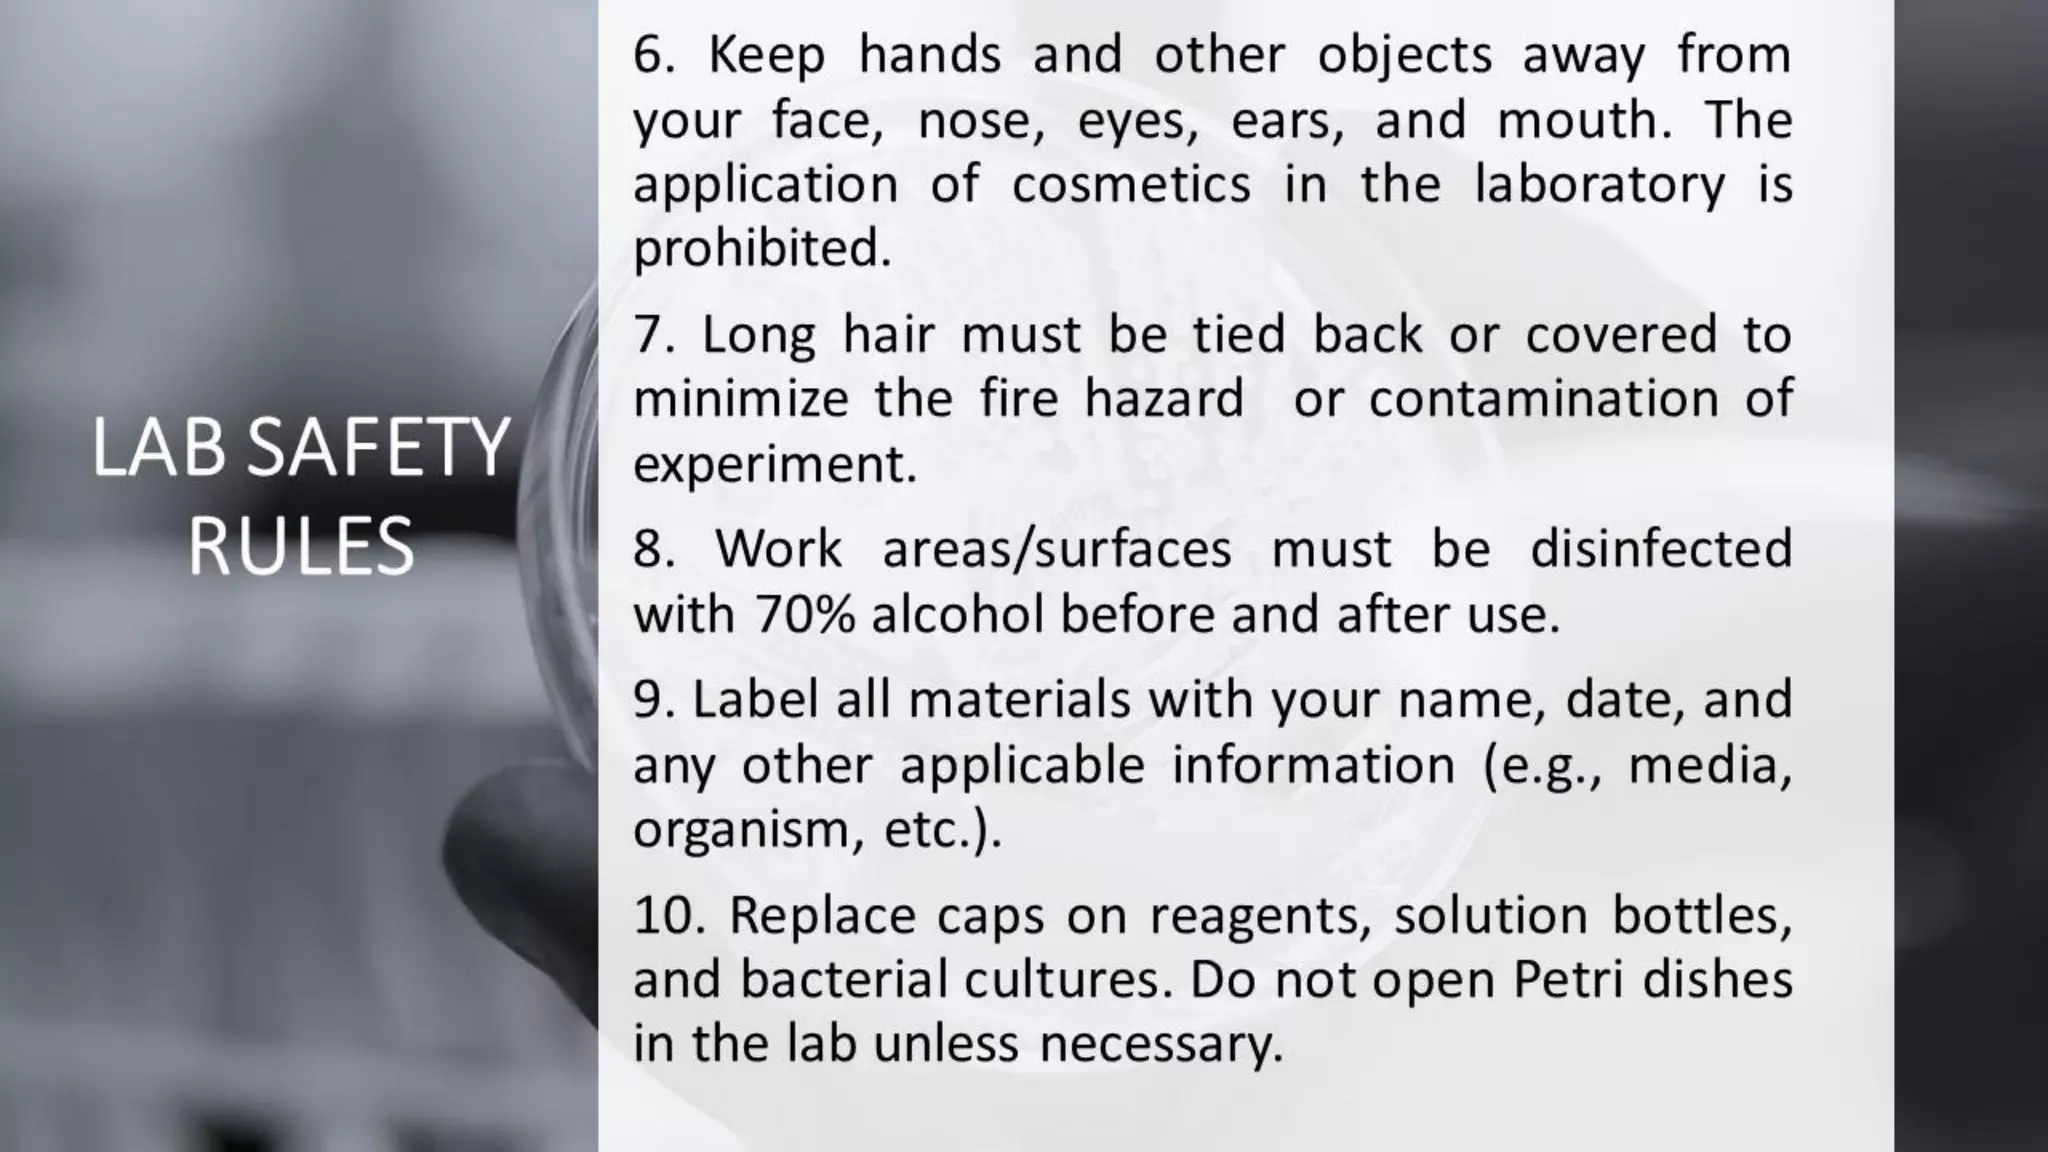

Microbiology Lab Safety : Microbiology Laboratory Safety and Rules
Di: Ava
Studying BIOL202 Microbiology with Lab at American Public University System? On Studocu you will find 25 coursework, 18 assignments, 14 essays and much more for MCB2010C Lab: Lab Safety Orientation Center for eLearning | FSCJ 2.92K subscribers Subscribed
LAB 1 Microbiology Lab Safety and General Procedures This lab has important safety information that will impact you throughout the course. Please read thoroughly, then complete the quiz on FOL to test your understanding. Keeping Safe in the Laboratory Working with microorganisms, especially pathogens, requires special equipment and safety practices. Biological hazards, also known as biohazards, refer to biological substances that pose a threat to the health of living organisms, especially humans. Instruments used in Microbiology Laboratory with Principle and Uses. These are the common instruments and equipment used in microbiology
Microbiology Lab Safety Rules Microbial Zoo (smtiquia) 9.5K subscribers Subscribed This video demonstrates the safety procedures for the microbiology lab at Mesa Community College CGCC Safety Procedures No eating or drinking in the lab. All food items must be placed outside the lab space. Do not apply cosmetics, lotion, Chap Stick, contact lenses while in the lab. Do not remove organisms from the lab or prep room. Use extreme caution around Bunsen burners. Open flames are the MOST dangerous thing in the microbiology lab!
10.3F: Safety in the Microbiology Laboratory
The instructions below are designed to keep you safe in the laboratory. Please read them carefully. If you have any questions about safe laboratory practices, ask your instructor. 1. No eating, drinking or smoking at any time. Do not bring food or drink items into the lab. Avoid all finger/hand-to-mouth contact. 2. A lab coat must be worn at all times in the microbiology
Test your knowledge on microbiology lab safety protocols and equipment with this quiz. Questions cover biosafety levels, hazards, and fire safety measures specific to the lab environment. Perfect for students and professionals looking to enhance their safety awareness in microbiology labs. Summary Regular risk assessment and safety training for lab staff Strict adherence to standard operating procedures (SOPs) Proper use of personal protective equipment (PPE) and containment devices Introduction In the United States, microbiology labs play a critical role in healthcare, Safety and Rules Use and Care of Microorganisms This area of science, may involve many dangers and hazards while experimenting. It is the sole responsibility of all teacher(s)/sponsor(s) to teach students proper safety methods and sterile techniques. Roles and Responsibilities of Students & Adults the Instructor is responsible for working with the student to evaluate any
Microbiology Lab Safety Pre-Lab Lab 1: Microbiology Lab Safety (100 points) Student Name: Amber Kierstead Student ID:7262692 Course ID: Each question on the lab worksheet must be answered completely, thoroughly, in complete sentences, and correctly in order to be considered for full credit If the question asks you to do research or find a source, a Chapter 12 Standard Safety Practices in the Microbiology Laboratory Laboratorians working with infectious agents are subject to laboratory-acquired infections through accidents or unrecognized incidents. The degree of hazard depends upon the virulence of the biological agent concerned and host resistance. Laboratory-acquired infections occur when microorganisms are
The normal activity in the laboratory of microbiology poses different risks – mainly biological – that can affect the health of their workers, visitors and the community. Routine health examinations (surveillance and prevention), individual awareness of self-protection, hazard identification and ris A food microbiology lab is extremely helpful in this situation. The foundation of food safety are these labs, which use cutting-edge methods Laboratory safety is essential for preventing accidents and ensuring a secure environment for scientific experimentation. Universal hazard labels, PPE, and
LABORATORY SAFETY AND STANDARDS PRECAUTIONS 6.1 INTRODUCTION Working in a laboratory usually involves working with various chemical, physical, and biological hazards. Because the hazards vary from laboratory to laboratory, employers must address the hazards specific to their laboratories. Biosafety levels help ensure the safety of lab personnel (and the environment) when working with potentially hazardous microbes. Safety in the clinical microbiology laboratory should not be taken for granted. It is paramount that scientists including those visiting the
Microbiology Laboratory Safety and Rules
Standard Operating Procedure for Laboratory Safety Purpose The purpose of this Standard Operating Procedure (SOP) is to establish procedures and guidelines for ensuring the safety of personnel working in the microbiology laboratory within the pharmaceutical manufacturing facility. Scope This SOP applies to all personnel working in the microbiology laboratory, including
Microbiology Laboratory Safety and Basic Procedures Safety in a microbiology laboratory is important in the prevention of infection that might be caused by the microorganisms being studied. This laboratory does not require the use of virulent human pathogens. However, many types of microorganisms are potentially pathogenic. This means that, although they would not cause
Hello learners,This video demonstrates the various lab safety measures you need to follow while working in a Microbiology Laboratory.Sometimes accidents do h Microbiology lab safety rules. Laboratory signs and symbols – View online for free This document outlines general safety rules and procedures for working in a medical microbiology laboratory. It discusses hazards such as exposure to biological agents, chemicals, radiation, and electrical accidents. The key safety practices include wearing personal protective equipment, keeping work areas clean and uncluttered, properly storing chemicals and biological materials,
A microbiology laboratory is a unique environment that requires special practices and containment facilities in order to properly protect persons working with microorganisms. Safety in the laboratory is the primary concern. The three main elements of safe containment of microorganisms are (1) good laboratory practices and technique, (2) safety equipment, and (3) facility design. The microbiology laboratory will give you the opportunity to develop new skills, apply critical thinking to solve problems and work independently on a multi-week project culminating in a written report. Today we will be reviewing basic microbiology lab safety, and waste disposal methods.
About Press Copyright Contact us Creators Advertise Developers Terms Privacy Policy & Safety How YouTube works Test new features NFL Sunday Ticket © 2025 Google LLC Always wear properly fitted and inspected TRU laboratory mandated personal protective equipment when handling any laboratory chemical: safety glasses or goggles, closed toed shoes, laboratory coat, and gloves. Wash hands before and after the use of disposable gloves. heating protocols and other chemical manipula
Study with Quizlet and memorize flashcards containing terms like The lab can be a safe place to work if, What is one of the main objectives of the laboratory portion of this course?, What microorganisms can be dangerous to your health? and more. Info Download AI Tools Microbiology La b Safety Pre-Lab Lab 1: Microbiolo gy Lab Safety (100 points) Student Name: Preparation Safety guidelines Risk assessment Good microbiological laboratory practice (GMLP) Spillage management Aerosols
SOP for Laboratory Safety
0 0 Save Microbiology La b Safety Pre-Lab Lab 1: Microbiolo gy Lab Safety (100 points) Student Name: Ipi nder Kaur Student ID: 7062085 Course ID: BIO L2 02 -Each question on the lab worksheet must be answered completely, thoroughly, in complete sentences and correctly in order to be considered for full credit -If t he question asks you to do r esearch or f ind a source, Figure: Biosafety Cabinets. Image Source: Pro-Lab Diagnostics. Biosafety cabinets are classified into three classes by the U.S. Centers for Disease Control and Prevention (CDC), each with specific performance characteristics and applications. Class I and II Biosafety cabinets are used for Biosafety levels I and II but, when used correctly in conjunction with useful
List of All SOPs and Documents for the Microbiology Laboratory 1. STANDARD OPERATING PROCEDURE FOR SWAB ANALYSIS 2. STANDARD OPERATING PROCEDURE FOR MICROBIAL ANALYSIS OF WATER 3. STANDARD OPERATING PROCEDURE FOR THE PRESENCE OF SPECIFIC PATHOGENS SALMONELLA OR E.COLI IN ANIMAL URINE 4.
- Michelin Radzierblende Preisvergleich
- Mietspiegel Und Immobilienpreise Von Langen Bei Bremerhaven
- Midi Controller: Akai Midimix _ AKAI MIDIMIX control surface released
- Michael Kelly Vermögen 2024: Biografie, Einkommen, Karriere, Auto
- Mietwohnungen Bis 70 M² In Längenfeld, Imst
- Michelin Sutthausen Map , MICHELIN-Landkarte Italien
- Mietverbot: Touristen Raus Aus Den Innenstädten
- Mietwagen In Salzburg Jetzt Günstig Buchen!
- Mietspiegel Herrenbach 2024: Aktuelle Mietpreise Und Trends
- Mieten Haus Mieten, Häuser Zur Miete In Renningen
- Microlearning: Was Es Ist Und Warum Es Sie Interessieren Sollte
- Mietpark Allgemeine Geschäftsbedingungen
- Mietwohnungen Husum, Mietwohnung
- Mickey Mouse Birthday Ideas : Mickey Mouse Clubhouse Party Ideas and Free Party Printables
- Michigan Designated Trauma Hospitals As Of January 2, 2024